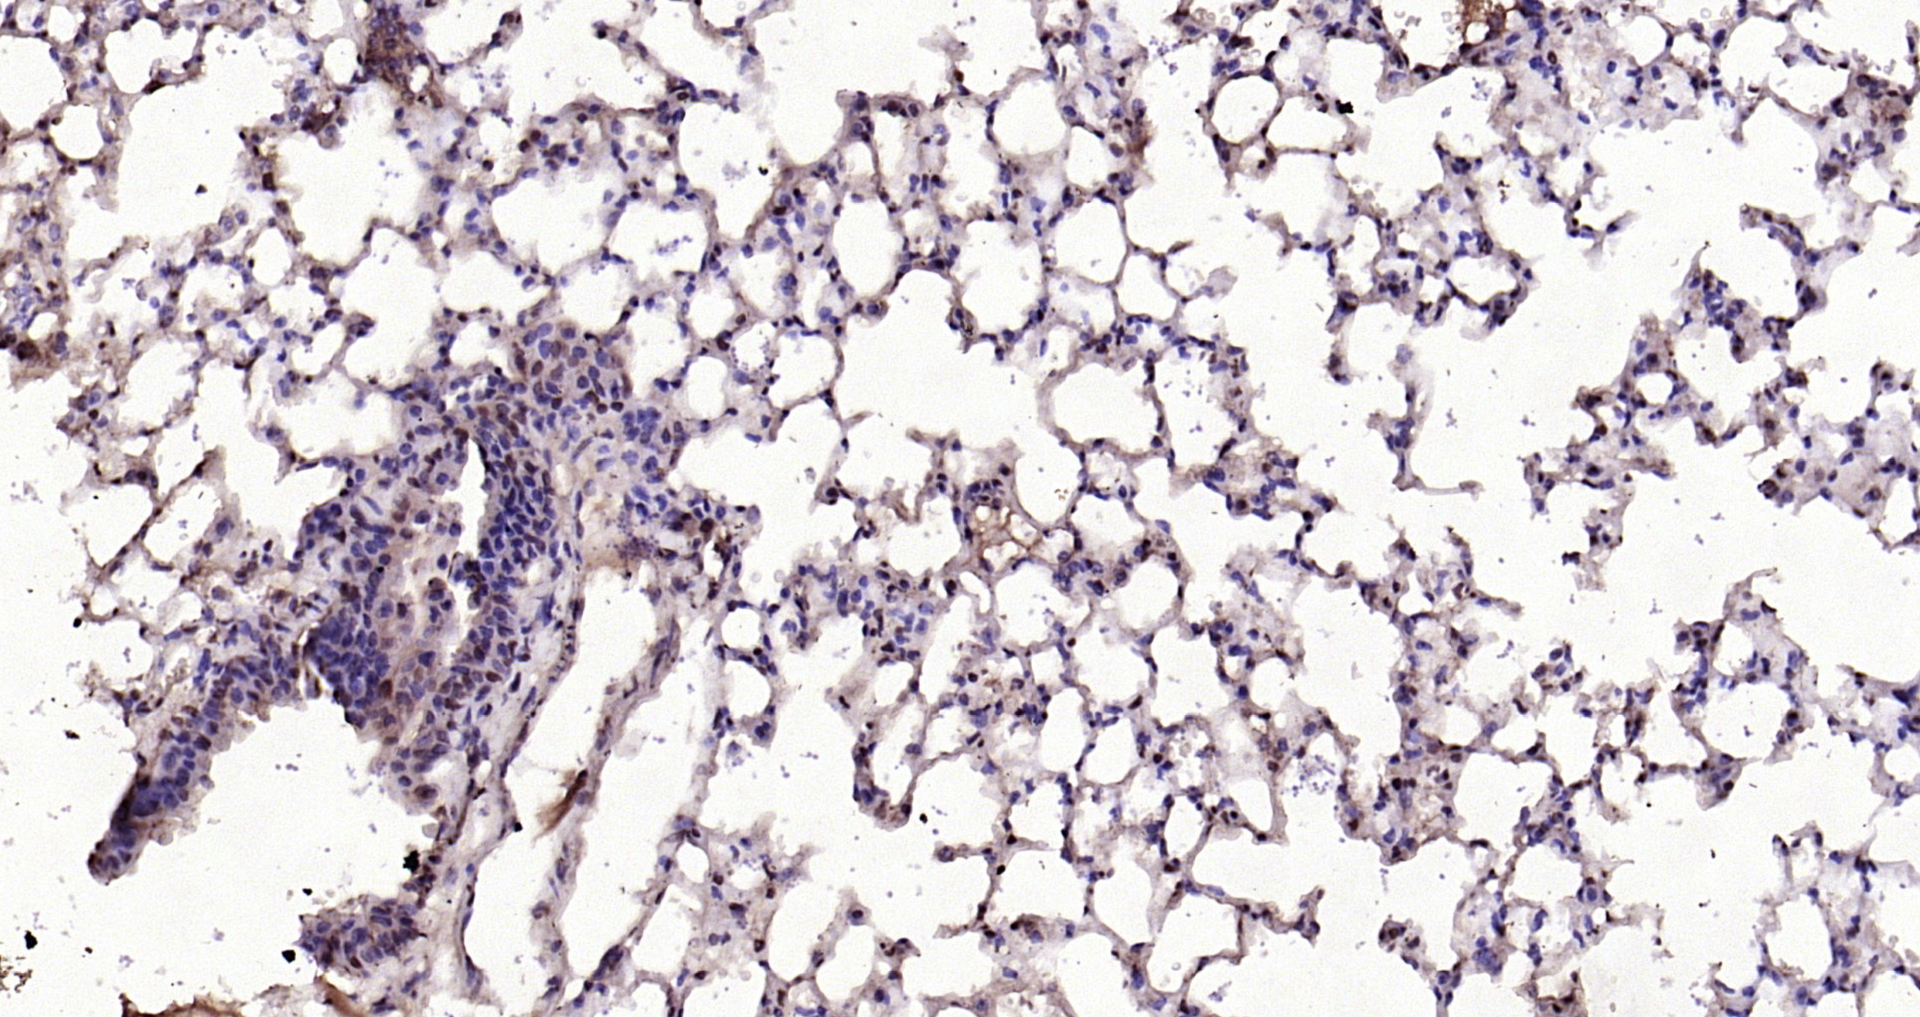
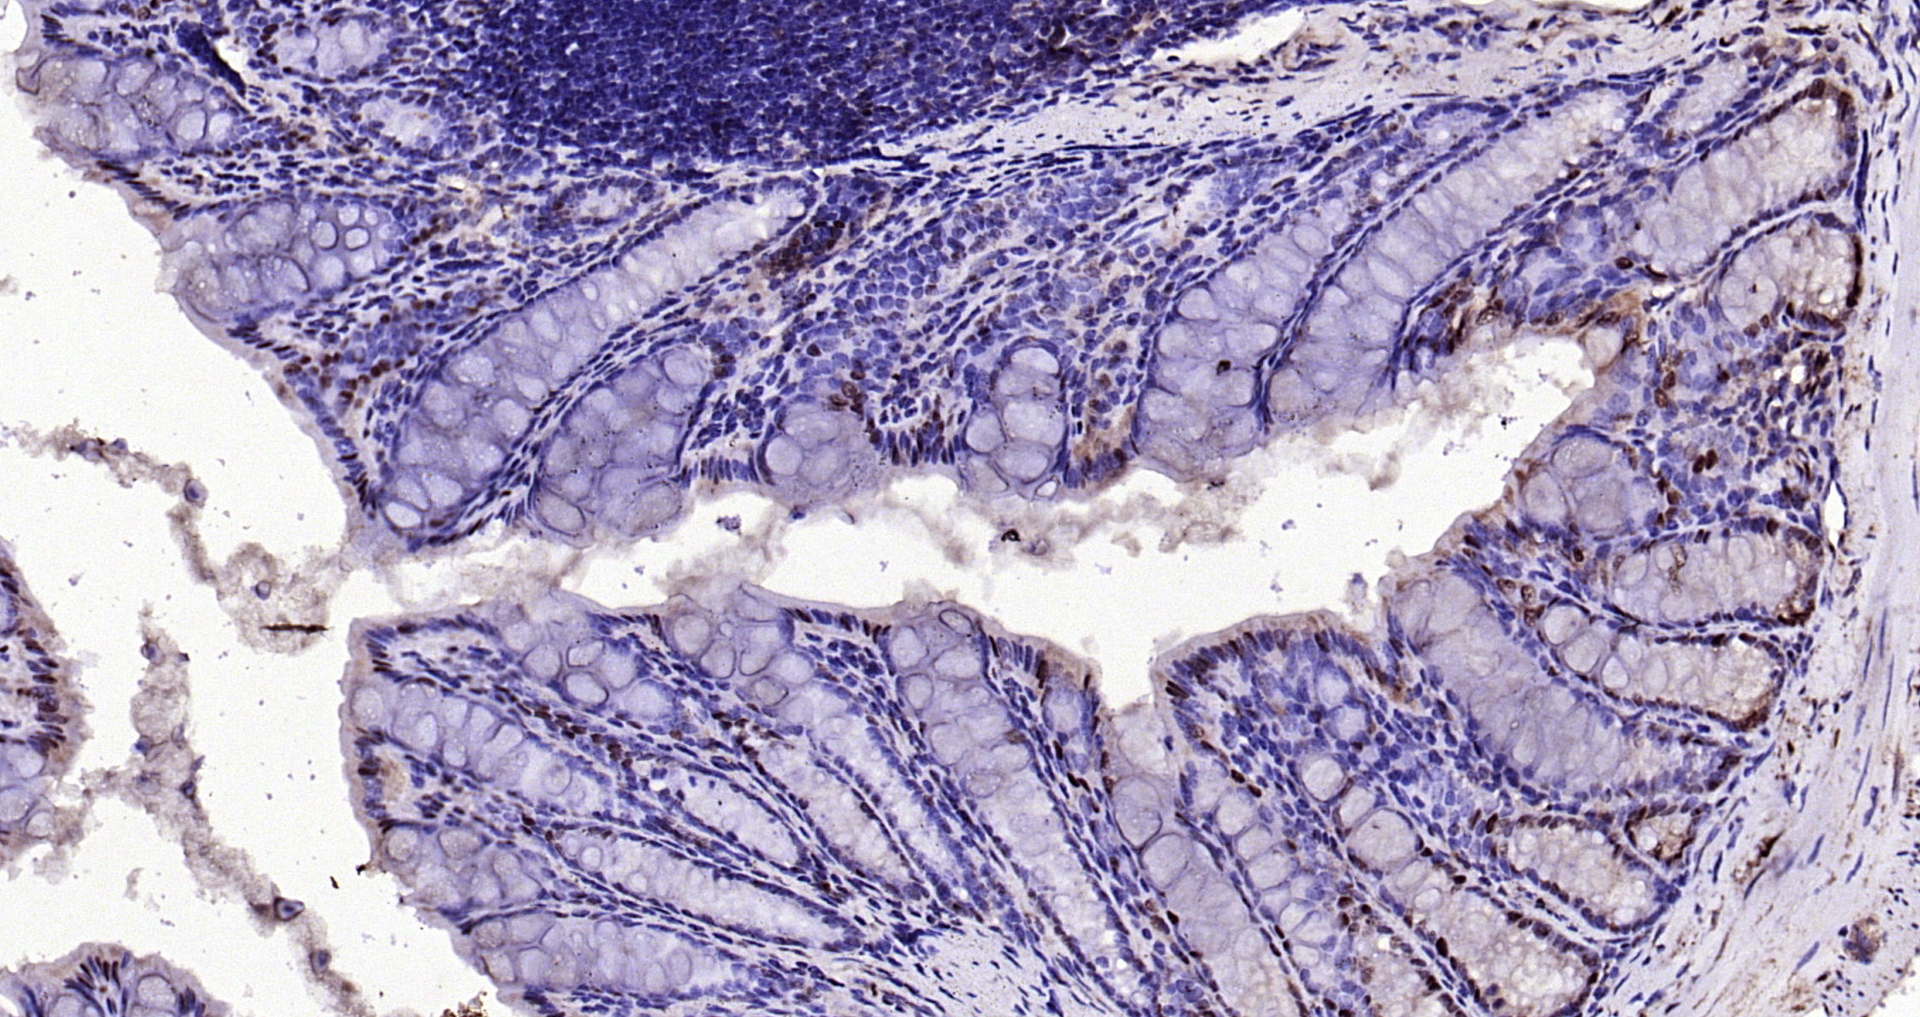

Paraformaldehyde-fixed, paraffin embedded rat lung; Antigen retrieval by boiling in sodium citrate buffer (pH6) for 15min; Block endogenous peroxidase by 3% hydrogen peroxide for 30 minutes; Blocking buffer (normal goat serum) at 37°C for 20min; Antibody incubation with Anti –IL-33 Polyclonal Antibody, Unconjugated (bs-2633R) at 1:200 overnight at 4°C, followed by a conjugated secondary for 90 minutes and DAB staining
IL33 Polyclonal Antibody
BS-2633R
ApplicationsFlow Cytometry, ImmunoFluorescence, ELISA, ImmunoCytoChemistry, ImmunoHistoChemistry, ImmunoHistoChemistry Frozen, ImmunoHistoChemistry Paraffin
Product group Antibodies
ReactivityMouse, Rat
TargetIl33
Overview
- SupplierBioss
- Product NameIL33 Polyclonal Antibody
- Delivery Days Customer16
- ApplicationsFlow Cytometry, ImmunoFluorescence, ELISA, ImmunoCytoChemistry, ImmunoHistoChemistry, ImmunoHistoChemistry Frozen, ImmunoHistoChemistry Paraffin
- Applications SupplierELISA(1:500-1000), FCM(1:20-100), IHC-P(1:200-400), IHC-F(1:100-500), IF(IHC-P)(1:50-200), IF(IHC-F)(1:50-200), IF(ICC)(1:50-200)
- CertificationResearch Use Only
- ClonalityPolyclonal
- Concentration1 ug/ul
- ConjugateUnconjugated
- Gene ID77125
- Target nameIl33
- Target descriptioninterleukin 33
- Target synonyms9230117N10Rik, Il-33, Il1f11, NF-HEV, interleukin-33, nuclear factor from high endothelial venules
- HostRabbit
- IsotypeIgG
- Protein IDQ8BVZ5
- Protein NameInterleukin-33
- ReactivityMouse, Rat
- Storage Instruction-20°C
- UNSPSC41116161
References
- Effects of 1,25-dihydroxyvitamin D3 in an ovalbumin-induced allergic rhinitis model. Chen B et al., 2017 Jun, Int ImmunopharmacolRead this paper